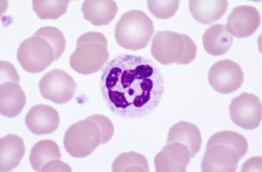

The ions attack harmful substances using the same mechanism as our bodies' own natural defenses.
The ions attack harmful substances using the same mechanism as our bodies' own natural defenses.
พวกเขาไม่สามารถมองเห็นได้ว่าในอากาศประกอบไปด้วย ละอองเกสรดอกไม้ สารที่ทำให้เกิดโรคภูมิแพ้ เชื้อรา ไวรัส และสารอันตรายอื่นๆ
ในปี พ.ศ. 2541 นักวิจัยของชาร์ป คาซูโอะ นิชิกาว่า ได้ศึกษาเทคโนโลยีของการฟอกอากาศในช่วงนั้น และได้ตระหนักว่าประสิทธิภาพในการใช้งานของเทคโนโลยีนี้ได้มาถึงขีดจำกัดแล้ว ต่อมาเครื่องฟอกอากาศก็ใช้แผ่นกรองที่สามารถจะดักสิ่งที่เป็นอันตรายได้ อย่างไรก็ตามในอนาคตวิธีฟอกอากาศแบบใหม่ๆ ก็ยังถูกคิดค้นขึ้นมาเรื่อยๆ ตราบใดที่ยังมีการสะสมตัวของฝุ่น และเขาก็ยังสงสัยว่านั่นจะเพียงพอหรือไม่ คุณนิชิกาว่าถูกกระตุ้นด้วยความคิดในเรื่องอากาศในห้องนอนของลูกที่เต็มไปด้วยซากของไรฝุ่นรวมทั้งพวกเชื้อรา ไวรัส และสารอันตรายอื่นๆ
คุณนิชิกาว่าวิตกกังวลต่อการที่ต้องสูดดมทุกสิ่งที่ว่าเข้าไปตอนเขาหลับ และนั่นทำให้เขาต้องทำอะไรซักอย่าง แล้วเขาก็คิดที่จะทำสิ่งใหม่ๆ ขึ้นมาให้สำเร็จ

คุณนิชิกาว่าและหัวหน้าทีมวิจัยในช่วงเวลานั้นได้ใช้เวลาไปมากกับการทดลองเพื่อให้ได้คำตอบ
ต่อมาไม่นานเขาก็สรุปได้ว่าแผ่นกรองอากาศมีข้อจำกัดคือสามารถกำจัดได้เพียงสารอันตรายที่ลอยมาติดที่ตัวกรองเท่านั้น “ถ้าจะต้องทำให้อากาศบริสุทธิ์จริงๆ จะต้องพัฒนาเทคโนโลยีเพื่อจะโจมตีสิ่งอันตรายในอากาศโดยตรง”
ในช่วงที่มีการระดมความคิดที่ติดตามผลอย่างใกล้ชิด หลายๆ สิ่งถูกนำมาพิจารณา
“เราต้องการบางสิ่งที่สามารถจับเชื้อโรคในอากาศได้โดยตรง”
ในตอนแรกนิชิกาว่าก็นึกถึงโอโซน เพราะโอโซนเป็นตัวออกซิไดเซอร์ที่มีประสิทธิภาพสูง และมีคุณสมบัติในการกำจัดกลิ่นและเชื้อแบคทีเรีย แต่เพื่อให้ทำงานได้อย่างมีประสิทธิภาพในอากาศ โอโซนจะต้องมีความเข้มข้นสูง และความเข้มข้นสูงของโอโซนก็จะเป็นพิษมากต่อสุขภาพของคนมาก มันก็แทบจะเป็นไปไม่ได้เลยที่จะนำไปใช้ในภายในอาคาร จึงต้องหาวิธีอื่น
ในช่วงเวลาเดียวกัน ผลิตภัณฑ์ที่สร้างประจุไฟฟ้าลบเพื่อช่วยในการผ่อนคลายก็กำลังได้รับความนิยม คุณนิชิกาว่าจึงคิดที่จะใช้มันในการฟอกอากาศ แต่หลังจากทดลองหลายครั้งก็พบว่า ประจุไฟฟ้าลบไม่มีประสิทธิภาพในการฆ่าเชื้อโรค คุณนิชิกาว่าก็ยังรู้สึกว่ามีอะไรบางอย่างที่ไม่เหมาะสม
ขณะที่ทำการทดสอบกับเชื้อโรคที่ลอยอยู่ในอากาศอย่างใกล้ชิด คุณนิชิกาว่าสังเกตเห็นว่าเชื้อโรคบางตัวก็มีประจุบวก บ้างก็มีประจุลบ เมื่อลองปล่อยแต่ประจุไฟฟ้าลบอย่างเดียว ก็อาจสามารถยับยั้งเชื้อโรคที่มีประจุลบได้ แต่ถ้าปล่อยพร้อมกันทั้งประจุบวกและลบ จะเกิดปฏิกิริยากับเชื้อโรคทั้งสองแบบหรือไม่?
แต่ประจุชนิดไหนล่ะที่จะนำมาใช้? มีหลากหลายให้เลือก แล้วประจุชนิดไหนที่จะส่งผลตามที่ต้องการ? คุณนิชิกาว่าจึงค้นคว้าอย่างจริงจังเพื่อหาคำตอบ
เขาเริ่มสงสัยว่าระบบภูมิคุ้มกันในร่างกายของเราอาจจะเป็นกุญแจไปสู่คำตอบ การที่เชื้อแบคทีเรียเข้าไปอยู่ในกระแสเลือด เม็ดเลือดขาวสู้กับเชื้อโรค การโจมตีเชื้อโรคและสิ่งแปลกปลอมอื่นๆ โดยปล่อยประจุ H+และประจุ O2- เราจะใช้วิธีเดียวกันในการกำจัดสิ่งแปลกปลอมในอากาศได้หรือไม่?
ความคิดที่จะใช้วิธีใหม่จึงเกิดขึ้นเป็นรูปเป็นร่าง
 เครื่องกำเนิดอนุภาคไฟฟ้าพลาสม่าคลัสเตอร์
เครื่องกำเนิดอนุภาคไฟฟ้าพลาสม่าคลัสเตอร์
ตัวกำเนิดประจุไฟฟ้าพลาสมาคลัสเตอร์
ผลที่ออกมาถูกต้องตามที่คาดเอาไว้ เมื่อประจุ H+และ O2- ที่ถูกปล่อยเข้าไปในห้องทดลองที่บรรจุเชื้อรา ไวรัส ซากและมูลของไรฝุ่น รวมทั้งสารก่อภูมิแพ้อื่นๆ พบว่าจำนวนของสิ่งเจือปนดังกล่าวในห้องลดลง
ในขณะเดียวกันนิชิกาว่าก็ค้นหาความจริงว่าประจุไฟฟ้าจะเป็นผลอันตรายต่อสุขภาพของคนหรือไม่ ประจุไฟฟ้าเหล่านี้พบกันมากในธรรมชาติ และก็เป็นประจุไฟฟ้าเช่นเดียวกับที่เราพบในชีวิตประจำวัน นอกจากนั้นแม้แต่ในที่ที่มีความเข้มข้นมากพอที่จะฆ่าเชื้อโรคได้ ความเข้มข้นของโอโซนก็ต้องถูกควบคุมให้ต่ำกว่า 0.01 ppm ที่ดูแล้วต่ำกว่าค่ามาตรฐาน 0.05 ppm ค่อนข้างมาก
เราได้พบชนิดของประจุไฟฟ้าที่จะนำมาใช้และทดสอบผลกระทบ เหตุผลที่แท้จริงว่าทำไมการกำจัดเชื้อโรคในอากาศด้วยประจุไฟฟ้าจึงยังไม่เป็นที่รู้จัก เพื่อจะหาคำตอบคุณนิชิกาว่าจึงติดต่อกับมหาวิทยาลัยและสถาบันวิจัยทุกแห่งที่เขารู้จักเพื่อขอความร่วมมือค้นคว้าทดลองผลกระทบนี้ แต่ก็ดูเหมือนไม่มีใครสนใจ เมื่อโชคชะตาเริ่มเข้าข้างเขา เขาแทบหมดกำลังใจและเกือบจะล้มเลิกความคิดที่จะทำต่อไป ในขณะเขาได้รับคำตอบจากมหาวิทยาลัยของประเทศเยอรมันที่สนใจในผลการศึกษาของเขา คุณนิชิกาว่าอยู่ระหว่างการเข้าร่วมประชุมวิชาการนานาชาติเพื่อจะแบ่งปันสิ่งที่เขาค้นพบ และเผยแพร่สิ่งที่เขาได้รับรู้ และหลังจากทั้งสองฝ่ายได้ทำงานร่วมกันกลไกที่ทำให้ประจุไฟฟ้าสามารถกำจัดเชื้อโรคจึงได้เกิดความกระจ่างในเวลาต่อมาไม่นาน
อธิบายอย่างง่ายๆ กลไกทำงานดังนี้: เมื่อประจุ H+และ O2- เข้าไปอยู่ใกล้กับเชื้อโรคที่อยู่ในอากาศ ประจุจะรวมตัวกันเองและก่อตัวเป็น OH ที่เป็นตัวออกซิไดซ์อย่างดี OH ก็จะดึงเอาไฮโดรเจนจากโปรตีนที่ห่อหุ้มเนื้อเยื่อชั้นนอกของเชื้อโรคออกมา จนทำให้มันไม่สามารถมีชีวิตอยู่ต่อไปได้
ด้วยวิธีการปล่อยประจุ H+และ O2- เพื่อทำให้อากาศบริสุทธิ์ปลอดจากสารอันตราย เทคโนโลยี
พลาสมาคลัสเตอร์จึงกำเนิดขึ้น

เมื่อได้รับแนวความคิดที่จะนำเทคโนโลยีพลาสมาคลัสเตอร์ไปใช้ประโยชน์ มันก็ยังต้องพิสูจน์ให้โลกเห็นถึงผลลัพธ์ที่แท้จริง ตั้งแต่เริ่มโครงการนี้ คุณนิชิกาว่าได้พยายามหาสถาบันวิจัยที่จะเข้ามาร่วมทำการทดลองเพื่อหาข้อมูลเพิ่มเติมเพื่อพิสูจน์ข้อสรุป
มันไม่ใช่งานที่ง่ายเลย ที่จะทดลองกับสิ่งที่อันตรายและอาจติดเชื้อได้ และยังมีความเสี่ยงด้วย เพื่อที่จะให้การทดลองตัวอย่างเช่น เชื้อรามีความปลอดภัย จึงต้องขอเข้าไปร่วมทดลองกับหลายๆ สถาบันจนได้พบแห่งหนึ่งที่ตอบรับข้อเสนอด้วยความยินดี ยิ่งกว่านั้นจำนวนของศูนย์วิจัยที่สามารถทำการทดลองกับเชื้อไวรัสได้โดยตรงก็มีจำนวนจำกัด แม้จะเคยหมดกำลังใจแต่คุณนิชิกาว่าและทีมงานก็ยังคงติดต่อกับฝ่ายวิจัยในประเทศญี่ปุ่นและต่างประเทศอย่าง HYPERLINK "http://dict.longdo.com/search/สม่ำเสมอ,%20เนืองนิจ" สม่ำเสมอ
ในตอนที่ทีมงานพยายามหาผู้ที่จะมาร่วมมือ สมาคมบริการสุขภาพอิชิคาว่าก็ได้เห็นพ้องที่จะร่วมทำงานและให้ข้อมูลกับทีมงานที่แสดงถึงประสิทธิภาพของเทคโนโลยีพลาสมาคลัสเตอร์ที่สามารถต้านเชื้อราในอากาศ ไม่นานก็ได้ข้อมูลสนับสนุนเพิ่มเติมจากหลายสถาบัน ซึ่งให้ทั้งข้อมูลของเชื้อไวรัส สารก่อภูมิแพ้ และสารปนเปื้อนอื่นๆ จากการพิสูจน์ในคุณประโยชน์ของเทคโนโลยี
พลาสมาคลัสเตอร์ที่สะสมมาเรื่อยๆของแต่ละสถาบัน ชาร์ปก็ได้นำเอาการตลาดเชิงวิชาการนี้ไปใช้เป็นส่วนหนึ่งในกลยุทธ์ของการพัฒนาผลิตภัณฑ์
 จากการพิจารณาด้านสุขภาพและคุณภาพสิ่งแวดล้อมของพื้นที่ใช้สอย ผู้พัฒนากำลังก้าวไปข้างหน้า
จากการพิจารณาด้านสุขภาพและคุณภาพสิ่งแวดล้อมของพื้นที่ใช้สอย ผู้พัฒนากำลังก้าวไปข้างหน้า
ในปี 2543 เทคโนโลยีพลาสมาคลัสเตอร์เปิดตัวครั้งแรกในโลก โดยมากับเครื่องฟอกอากาศที่จัดจำหน่าย สำหรับคนที่เป็นห่วงในเรื่อง ซากและมูลไรฝุ่น รวมทั้งสารก่อภูมิแพ้อื่นๆ มากขึ้น เครื่องฟอกอากาศนี้ได้เป็นที่นิยมขึ้นมาอย่างฉับพลัน
ปี 2551 นับเป็นเวลา 9 ปีที่ตั้งแต่เริ่มมีเทคโนโลยีพลาสมาคลัสเตอร์ ความท้าทายของนิชิกาว่าก็ยังไม่สิ้นสุดลงเพียงแค่นั้น
“เราจะไม่หยุดเพียงแค่ให้ห้องปราศจากสิ่งเจือปนในอากาศ แต่เราจะกำจัดเชื้อแบคทีเรียและสลายกลิ่นที่ติดบนผ้าของคุณ” คุณนิชิกาว่ากล่าว และต่อมาเขาก็สามารถเพิ่มประสิทธิภาพให้กับเทคโนโลยีที่มีประจุไฟฟ้าเข้มข้นมากขึ้น เขาสามารถยับยั้งเชื้อราที่ติดอยู่ตามผนังและพื้นได้ ความสามารถในการทำให้ประจุไฟฟ้าเข้มข้นอย่างฉับพลัน แต่อาจจะต้องปรับให้เหมาะสมกับความต้องการของแต่ละอาคาร ทำให้สามารถฆ่าเชื้อโรคเฉพาะในบางจุดได้อย่างสมบูรณ์มากขึ้น
คุณนิชิกาว่ามีความมุ่งมั่นที่จะพัฒนาอุปกรณ์ใหม่ๆ “ชาร์ปได้ก่อตั้งขึ้นบนหลักการของการสร้างสรรค์สิ่งประดิษฐ์ใหม่ๆ ที่ทำให้ใครก็อยากเลียนแบบ วิศวกรที่นี่ทุกคนจะร่วมกันแบ่งปันความรับผิดชอบ”
“ตอนนี้เรามีแนวคิดใหม่เกี่ยวกับคุณภาพของอากาศที่เราหายใจ เมื่อเราสามารถกำจัดสิ่งอันตรายและสารก่อภูมิแพ้ออกไปได้ เทคโนโลยีพลาสมาคลัสเตอร์นั้นเป็นประโยชน์มากในบ้าน เราเริ่มจะเห็นผลจากการใช้งานในที่สาธารณะที่มีคนอยู่รวมกันมากๆ เราหวังว่าเราจะยังคงขยายขอบเขตการใช้งานไปในที่อื่นๆ อีก” คุณนิชิกาว่ากล่าว อย่างมุ่งมั่นเกี่ยวกับอนาคตที่ได้กำหนดแนวทางไว้
 The ions attack harmful substances using the same mechanism as our bodies' own natural defenses.
The ions attack harmful substances using the same mechanism as our bodies' own natural defenses.

เครื่องกำเนิดอนุภาคไฟฟ้าพลาสม่าคลัสเตอร์
เครื่องกำเนิดอนุภาคไฟฟ้าพลาสม่าคลัสเตอร์


 จากการพิจารณาด้านสุขภาพและคุณภาพสิ่งแวดล้อมของพื้นที่ใช้สอย ผู้พัฒนากำลังก้าวไปข้างหน้า
จากการพิจารณาด้านสุขภาพและคุณภาพสิ่งแวดล้อมของพื้นที่ใช้สอย ผู้พัฒนากำลังก้าวไปข้างหน้า